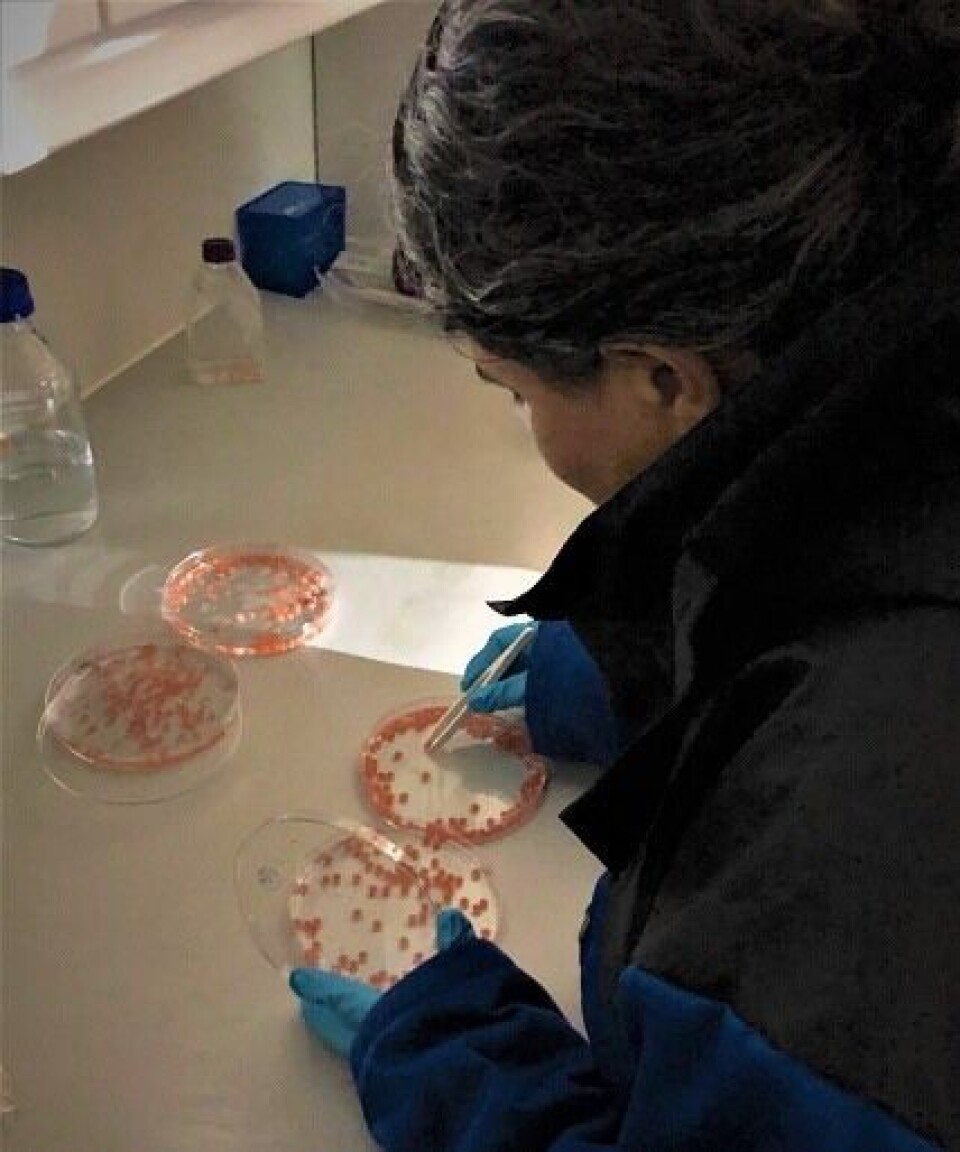

Bakterier på lakseskinn – har de noen funksjon?
Skinnet til fisk er dekket med et tykt og dynamisk slimlag som gir beskyttelse mot skadelige mikrober og partikler som finnes i vannet. Samtidig huser dette slimlaget særegne bakteriesamfunn som er svært forskjellig fra dem i vannet som omgir fisken.
Denne artikkelen er tre år eller eldre.
Er disse bakteriene tilfeldig fanget i slimet, eller er de aktivt rekruttert og lever i et gjensidig samspill med fisken? Bidrar de aktivt til å skape barrierefunksjonen i skinnoverflata? Dette forsøker vi å finne svar på i forskningsprosjektet MicroMucus.
Artikkelen er skrevet av Ingrid Bakke, Sol Gomez de la Torre Canny, Catherine Taylor Nordgård, Olav Vadstein, Karen Dunker, og Marit Sletmoen (NTNU Institutt for bioteknologi og matvitenskap)
I de siste årene har vi fått ny og overraskende kunnskap om hvor viktige bakteriesamfunn i tarmen (tarmmikrobiota) hos dyr og mennesker er for vertens helse. Bakterier er nødvendige for at tarmveggen skal oppnå gode barriereegenskaper. I tillegg bidrar de til energiopptak i tarmen, til utvikling av immunforsvaret, og regulering av betennelse i vev. Ubalanse i tarmmikrobiotaen har blitt knyttet til en rekke sykdommer, og kan til og med påvirke mental helse.
Fisk lever i direkte kontakt med vann, og i motsetning til hos landdyr, er fiskens skinnoverflate dekket av et beskyttende slimlag (mucus). Dette mucuslaget har mange fellestrekk med slimet som dekker tarmveggen hos dyr, og er i likhet med tarmmucus bebodd av komplekse bakteriesamfunn (mikrobiota), helt forskjellig fra de man finner i omgivelsene. Fiskeskinnsmikrobiotaen varierer mellom fiskearter, mellom individer i ulike miljø (for eksempel laks i ferskvann og sjøvann), og mellom kroppsdeler på et individ. Hvorfor fiskeskinnsmucus er kolonisert av bakterier, og hvilken funksjon de eventuelt har i denne slimbarrieren, er det ingen som vet.
I prosjektet MicroMucus («Microbial contributions to the Atlantic salmon (Salmo salar) skin mucosal barrier»), finansiert av FriPro-programmet til Norges forskningsråd, bruker vi en tverrfaglig tilnærming for å undersøke hvordan bakterier påvirker skinnbarrieren hos plommesekkyngel av laks. Prosjektet ledes fra Institutt for bioteknologi og matvitenskap ved NTNU, og er basert på ekspertise ved instituttet innenfor blant annet mucusbiologi, nanoteknologi, mikrobiell økologi, utviklingsbiologi hos fisk og bakteriefritt fiskehold.
Bakteriefrie plommesekkyngel
Den kunnskapen som finnes om tarmmikrobiotaens funksjon, er i stor grad basert på korrelasjoner mellom sykdom og tilstedeværelsen av spesifikke bakterier i tarmmikrobiotaen. Men for å vise faktiske årsakssammenhenger, har bakteriefrie og såkalte gnotobiotiske dyremodeller vært avgjørende. I gnotobiotiske modellsystemer er dyrene født i bakteriefrie omgivelser, og forskerne kan deretter tilsette utvalgte bakteriestammer. Et gnotobiotisk dyr er dermed kolonisert på en kontrollert måte, og sammensetningen til dyrets mikrobiota er kjent. Ved å sammenlikne med bakteriefrie dyr, kan man identifisere prosesser i verten som er påvirket eller regulert av bakterier. Mus og sebrafisk har vært de viktigste gnotobiotiske dyremodellene så langt.
I dette prosjektet har vi utviklet et modellsystem der vi kan holde lakseyngel bakteriefrie gjennom hele plommesekkfasen. Eggene desinfiseres før klekking og holdes så i sterile omgivelser, fullstendig fri for mikrober. Vi kan deretter tilsette bakterier, enten veldefinerte bakterieisolater, eller uspesifiserte bakteriesamfunn, som for eksempel i form av vann fra en naturlig kilde eller et settefiskanlegg. Ved å sammenlikne skinnoverflata hos bakteriefrie yngel med yngel som har levd i nærvær av bakterier, kan vi undersøke bakterienes rolle og funksjon i skinnbarrieren.

Plommesekkyngel av laks har egenskaper som gir nye muligheter i studier av vert – mikrobe-interaksjoner. For det første er plommesekkfasen lang. Fôring medfører ofte komplikasjoner i bakteriefrie systemer, men her kan vi studere samspillet mellom bakterier og yngel over relativt lang tid (rundt 12 uker), uten å måtte tilføre bakteriefritt fôr. For det andre er laksens egg og plommesekkyngel relativt store, noe som forenkler det praktiske arbeidet og muliggjør bruk av et stort antall ulike analyseverktøy. For det tredje gjør dette modellsystemet det mulig å studere egenskapene til mucusoverflater på levende individ. Dette sikrer at overflaten beholder sin tredimensjonale organisering, og sannsynligheten øker derfor for at den har sine naturlige, biologiske egenskaper intakt. Den eksperimentelle tilnærmingen vi har valgt i dette studiet gir derfor et nytt bidrag til mucusforskningen, som tidligere stort sett har vært utført på slim som er fjernet fra sine naturlige, biologiske overflater. En annen fordel er at det bare trengs enkelt laboratorieutstyr til å avle bakteriefrie og gnotobiotiske lakseyngel. I motsetning til i gnotobiotiske modellsystemer for mus, kan vi derfor bruke robuste forsøksdesign med store antall individer og replikater for ulike eksperimentelle betingelser.
Laksens skinnmucus – en kompleks og heterogen slimoverflate
Et viktig mål i prosjektet har vært å karakterisere skinn-slimhinna hos plommesekkyngelen. Vi har undersøkt elastisitet og viskositet (reologi), samt tykkelse på slimlaget, og er overrasket av hvor kompleks og heterogen denne mucusoverflata er. En del av mucus er fast og sitter godt festet til skinnet, mens annet er mer viskøst og løsere assosiert med fisken. Dette skilles trolig raskt ut, sånn at fisken kan bli kvitt mikroorgansimer og andre partikler som er fanget der. Fisken kan på denne måten tilpasse seg stadig skiftende miljøer. Gjennom plommesekkfasen ser vi at det faste slimlaget blir tjukkere, mens det løse slimlaget blir sterkere.
Bakteriene påvirker egenskapene til skinnmucus
Resultater oppnådd i prosjektet viser at bakteriefrie fisk har et tynnere lag med fast mucus, samtidig som det løse slimlaget er mindre sterkt og blir lettere blir deformert enn hos yngel som har levd i nærvær av bakterier. Vi har også observert at selve hudlaget til bakteriefrie yngel er tynnere. Disse funnene er spennende, fordi det indikerer at bakterier bidrar til barrierefunksjonen og er med på å kontrollere homeostase i skinnmucus-overflata. Mer forskning er nødvendig for å undersøke om dette skjer ved hjelp av liknende mekanismene som tidligere er beskrevet for bakterie – vert-interaksjoner i tarmmucus hos mus.

Vi har også brukt atomær kraftmikroskopi (AFM) til å bestemme den mekaniske styrken til skinnmucus på hel yngel. Forsøkene blir utført ved å pressen en liten og svært tynn probe ned i materialet mens man måler motstanden, og metoden kalles nanoindentering. Disse analysene viste at slimlaget blir sterkere og fastere med økende alder.
Bakteriefrie plommesekkyngel av laks – videre forskning
Vi arbeider nå med å sluttføre arbeidet beskrevet over, og undersøker også hvordan uttrykket av yngelens gener blir påvirket av bakteriefrie omgivelser. Dette kan bidra til å forklare hvordan bakterier påvirker fiskens skinnmucus på et molekylært nivå.
Vi ønsker å bruke dette modellsystemet i nye forskningsprosjekter for å studere samspillet mellom bakterier og fisk videre. Med bakgrunn i kunnskap vi har oppnådd i Micromucus, er relevante forskningsspørsmål for eksempel: Kan noen bakterier forbedre barrierefunksjonen til mucusoverflater og dermed gjøre fisken mer motstandsdyktig? Kan en probiotisk behandling i plommesekkfasen styrke fisken og gjøre den mer robust i seinere livsstadier? Gir fiskens naturlige mikrobiota beskyttelse mot infeksjoner?
Til tross for stor forskningsaktivitet er det fremdeles mye vi ikke vet om hvordan bakterier virker inn på dyr og mennesker sin helse. Når det gjelder interaksjoner mellom bakterier i skinnmucus og fisk, er forskningen fremdeles i startgropa. Det overordnede målet for vår forskning på dette feltet er todelt: For det første ønsker vi å forbedre den grunnleggende forståelsen av hvordan bakterier samhandler med og påvirker verten sin. For det andre vil vi undersøke potensialet for å bruke positive bakterie – fisk-interaksjoner til å forbedre fiskehelse, noe som på sikt vil bidra til bærekraftig produksjon av matfisk i akvakulturnæringa.